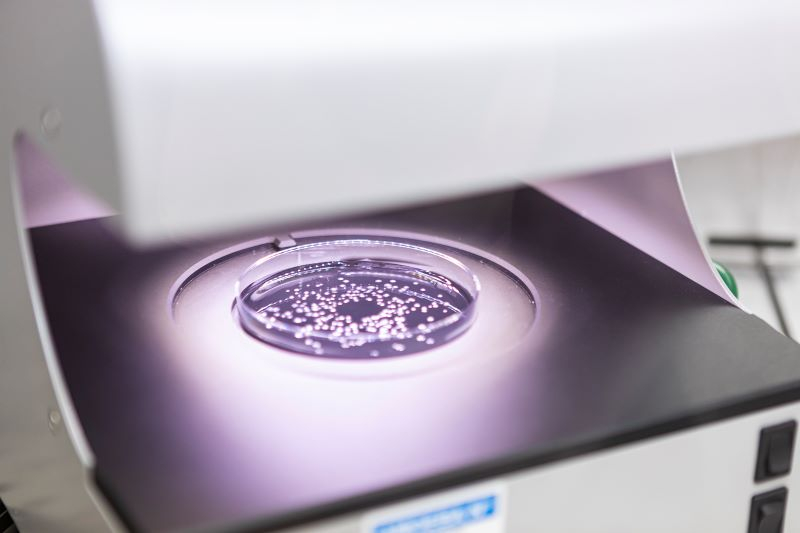
Биологические инновации в защите зерновых и полевых культур

Syngenta и Amoeba SA разработают и коммерциализируют решения по биозащите сельскохозяйственных культур в ЕС и Великобритания Великобритания
Амеба. Эти одноклеточные микроорганизмы стали основой одной из самых прорывных биологических инноваций в сельском хозяйстве — биофунгицида, способного защитить пшеницу и другие зерновые от разрушительных грибковых заболеваний, которые ежегодно обходятся мировому аграрному сектору в миллиарды долларов потерь урожая и качества.
Этот новый препарат, изготовленный из лизата амебы Willaertia magna C2c Maky, обладает значительным потенциалом для разработки средств биологической защиты растений. В ходе испытаний препарат продемонстрировал высокую эффективность в борьбе с грибами, вызывающими эти заболевания, и помог активировать естественные защитные механизмы растений. Являясь биологическим препаратом нового поколения, он создан на основе биологически активного вещества и предназначен для комплексного применения в современном растениеводстве.
Syngenta Crop Protection, мировой лидер в области биологических и других инновационных технологий защиты растений, и французский новатор в области экологических технологий Amoéba SA подписали Меморандум о взаимопонимании по разработке и коммерциализации инновационных биологических препаратов для защиты растений на рынках ЕС и Великобритании, уделяя особое внимание зерновым и полевым культурам. Стороны планируют согласовать окончательное дистрибьюторское соглашение к весне 2026 года.
Данное стратегическое сотрудничество направлено на обеспечение фермеров передовыми биологическими решениями, повышающими устойчивость их сельскохозяйственных технологий, решающими проблему растущей устойчивости вредителей к существующим препаратам и упрощающими доступ фермеров к альтернативным видам защиты растений в условиях все более ограниченного арсенала средств защиты растений.

Борьба с основными болезнями пшеницы
Первоначально партнерство будет сосредоточено на борьбе с основными болезнями пшеницы, септориозной пятнистостью (STB) и желтой ржавчиной. Эти две болезни являются одними из наиболее экономически разрушительных для пшеницы в Европе и Великобритании, поражая, по оценкам, 9-12 миллионов гектаров каждый год. Согласно признанным отраслевым и научным источникам, только в Германии септориоз вызывает потери урожая на 5–50 % и убытки в размере 1,5 миллиарда евро в год, тогда как желтая ржавчина может снизить урожайность на 10–70 %, а у восприимчивых сортов привести к полной потере урожая.
Мэтью Пикард, руководитель подразделения Syngenta по обработке семян и биологическим препаратам в Европе, сказал: «В Syngenta мы стремимся предоставлять инновационные, эффективные биологические решения на переднем крае науки. Мы гордимся тем, что сотрудничаем с Amoéba и совместно предлагаем вдохновленные природой решения, которые открывают новые возможности для фермеров на этих важных рынках».
«Мы очень рады работать с Syngenta, мировым лидером в области агроинноваций», — подтвердили Бенуа Виллер, председатель совета директоров Amoéba, и Жан-Франсуа Дусе, генеральный директор Amoéba. «Это соглашение, которое должно привести к партнерству в сфере дистрибуции и развития между нашими компаниями, является важным шагом для Amoéba. Оно позволяет нам объединить наш научный опыт с признанным лидерством Syngenta в области защиты зерна и маркетинга решений по биобезопасности. Это яркий пример того, как сотрудничество между новаторами в этом секторе может изменить ситуацию к лучшему для фермеров, открывая путь к более широкому применению защиты в полевых культурах».
Об инновациях Amoéba
Основанная в 2010 году компания Amoéba разработала запатентованное решение в области биобезопасности на основе лизата амебы Willaertia magna, которое в октябре 2025 года получило престижную золотую медаль Бернара Блюма как самый многообещающий в мире биологический препарат для защиты растений. В июне 2025 года активное вещество получило одобрение ЕС после научной оценки EFSA и решения Европейской комиссии. Разрешения на конкретные продукты находятся в стадии оформления.
Syngenta — мировой лидер в области сельскохозяйственных инноваций, присутствующий более чем в 90 странах. Syngenta сосредоточена на разработке технологий и методов ведения сельского хозяйства, которые позволят фермерам осуществить преобразования, необходимые для того, чтобы накормить мир, сохраняя при этом окружающую среду. Ее смелые научные открытия приносят больше пользы фермерам и обществу в большем масштабе, чем когда-либо прежде. Руководствуясь своими приоритетами в области устойчивого развития, Syngenta разрабатывает новые технологии и решения, которые помогают фермерам выращивать более здоровые растения на более здоровой почве с более высокими урожаями. Штаб-квартира Syngenta Crop Protection находится в Базеле, Швейцария; Штаб-квартира Syngenta Seeds находится в США.
Amoéba основанная в 2010 году компания Amoéba — это экологически технологичная компания со штаб-квартирой в Шасье (Лион, Франция), целью которой является стать ведущим игроком в борьбе с микробиологическими рисками на основе запатентованного использования амеб в секторах защиты растений и косметики.
Обладая уникальными в мире ноу-хау, защищенными многочисленными патентами, Amoéba в настоящее время является единственной компанией, способной использовать весь потенциал амебы *Willaertia* в промышленных масштабах и выращивать ее в достаточных количествах, чтобы предложить биологические решения, которые представляют собой реальную альтернативу широко используемым сегодня химическим продуктам. В настоящее время Amoéba специализируется на мировом рынке биоконтроля средств защиты растений и косметических средств.
Amoéba котируется на Euronext Growth (ALMIB). Компания является членом сети Bpifrance Excellence и соответствует требованиям схемы PEA-PME.
